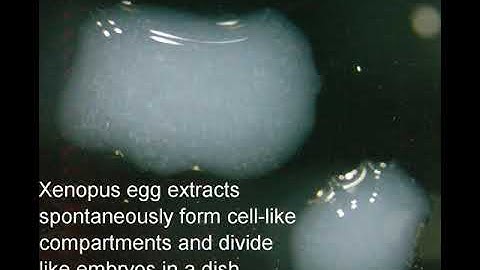
Frog (Xenopus laevis) egg extract carrying out cell cycles and divisions in a dish

⬇ DOWNLOAD NOW
Jika muncul iklan pop-up, tutup lalu klik tombol kembali
Download lagu Cell-like compartments form and divide in a Xenopus egg extract secara gratis hanya untuk keperluan promosi. Dukung artis favorit kamu dengan membeli musik original di iTunes atau platform resmi lainnya.
 Scrambled frog eggs self-organize into cell-like compartments and the compartments divide like cells
Scrambled frog eggs self-organize into cell-like compartments and the compartments divide like cells Scrambled frog eggs self-organize into compartments that divide like cells
Scrambled frog eggs self-organize into compartments that divide like cells Scrambled frog eggs self-organize into cell-like comparments
Scrambled frog eggs self-organize into cell-like comparments Frog (Xenopus laevis) egg extract carrying out cell cycles and divisions in a dish
Frog (Xenopus laevis) egg extract carrying out cell cycles and divisions in a dish A Xenopus egg extract carrying out more than 24 cycles (over 14 hours) in vitro
A Xenopus egg extract carrying out more than 24 cycles (over 14 hours) in vitro Preparation and Fractionation of Xenopus Laevis Egg Extracts
Preparation and Fractionation of Xenopus Laevis Egg Extracts In Vitro Nuclear Assembly Using Fractionated Xenopus Egg Extracts l Protocol Preview
In Vitro Nuclear Assembly Using Fractionated Xenopus Egg Extracts l Protocol Preview In Vitro Nuclear Assembly Using Fractionated Xenopus Egg Extracts
In Vitro Nuclear Assembly Using Fractionated Xenopus Egg Extracts